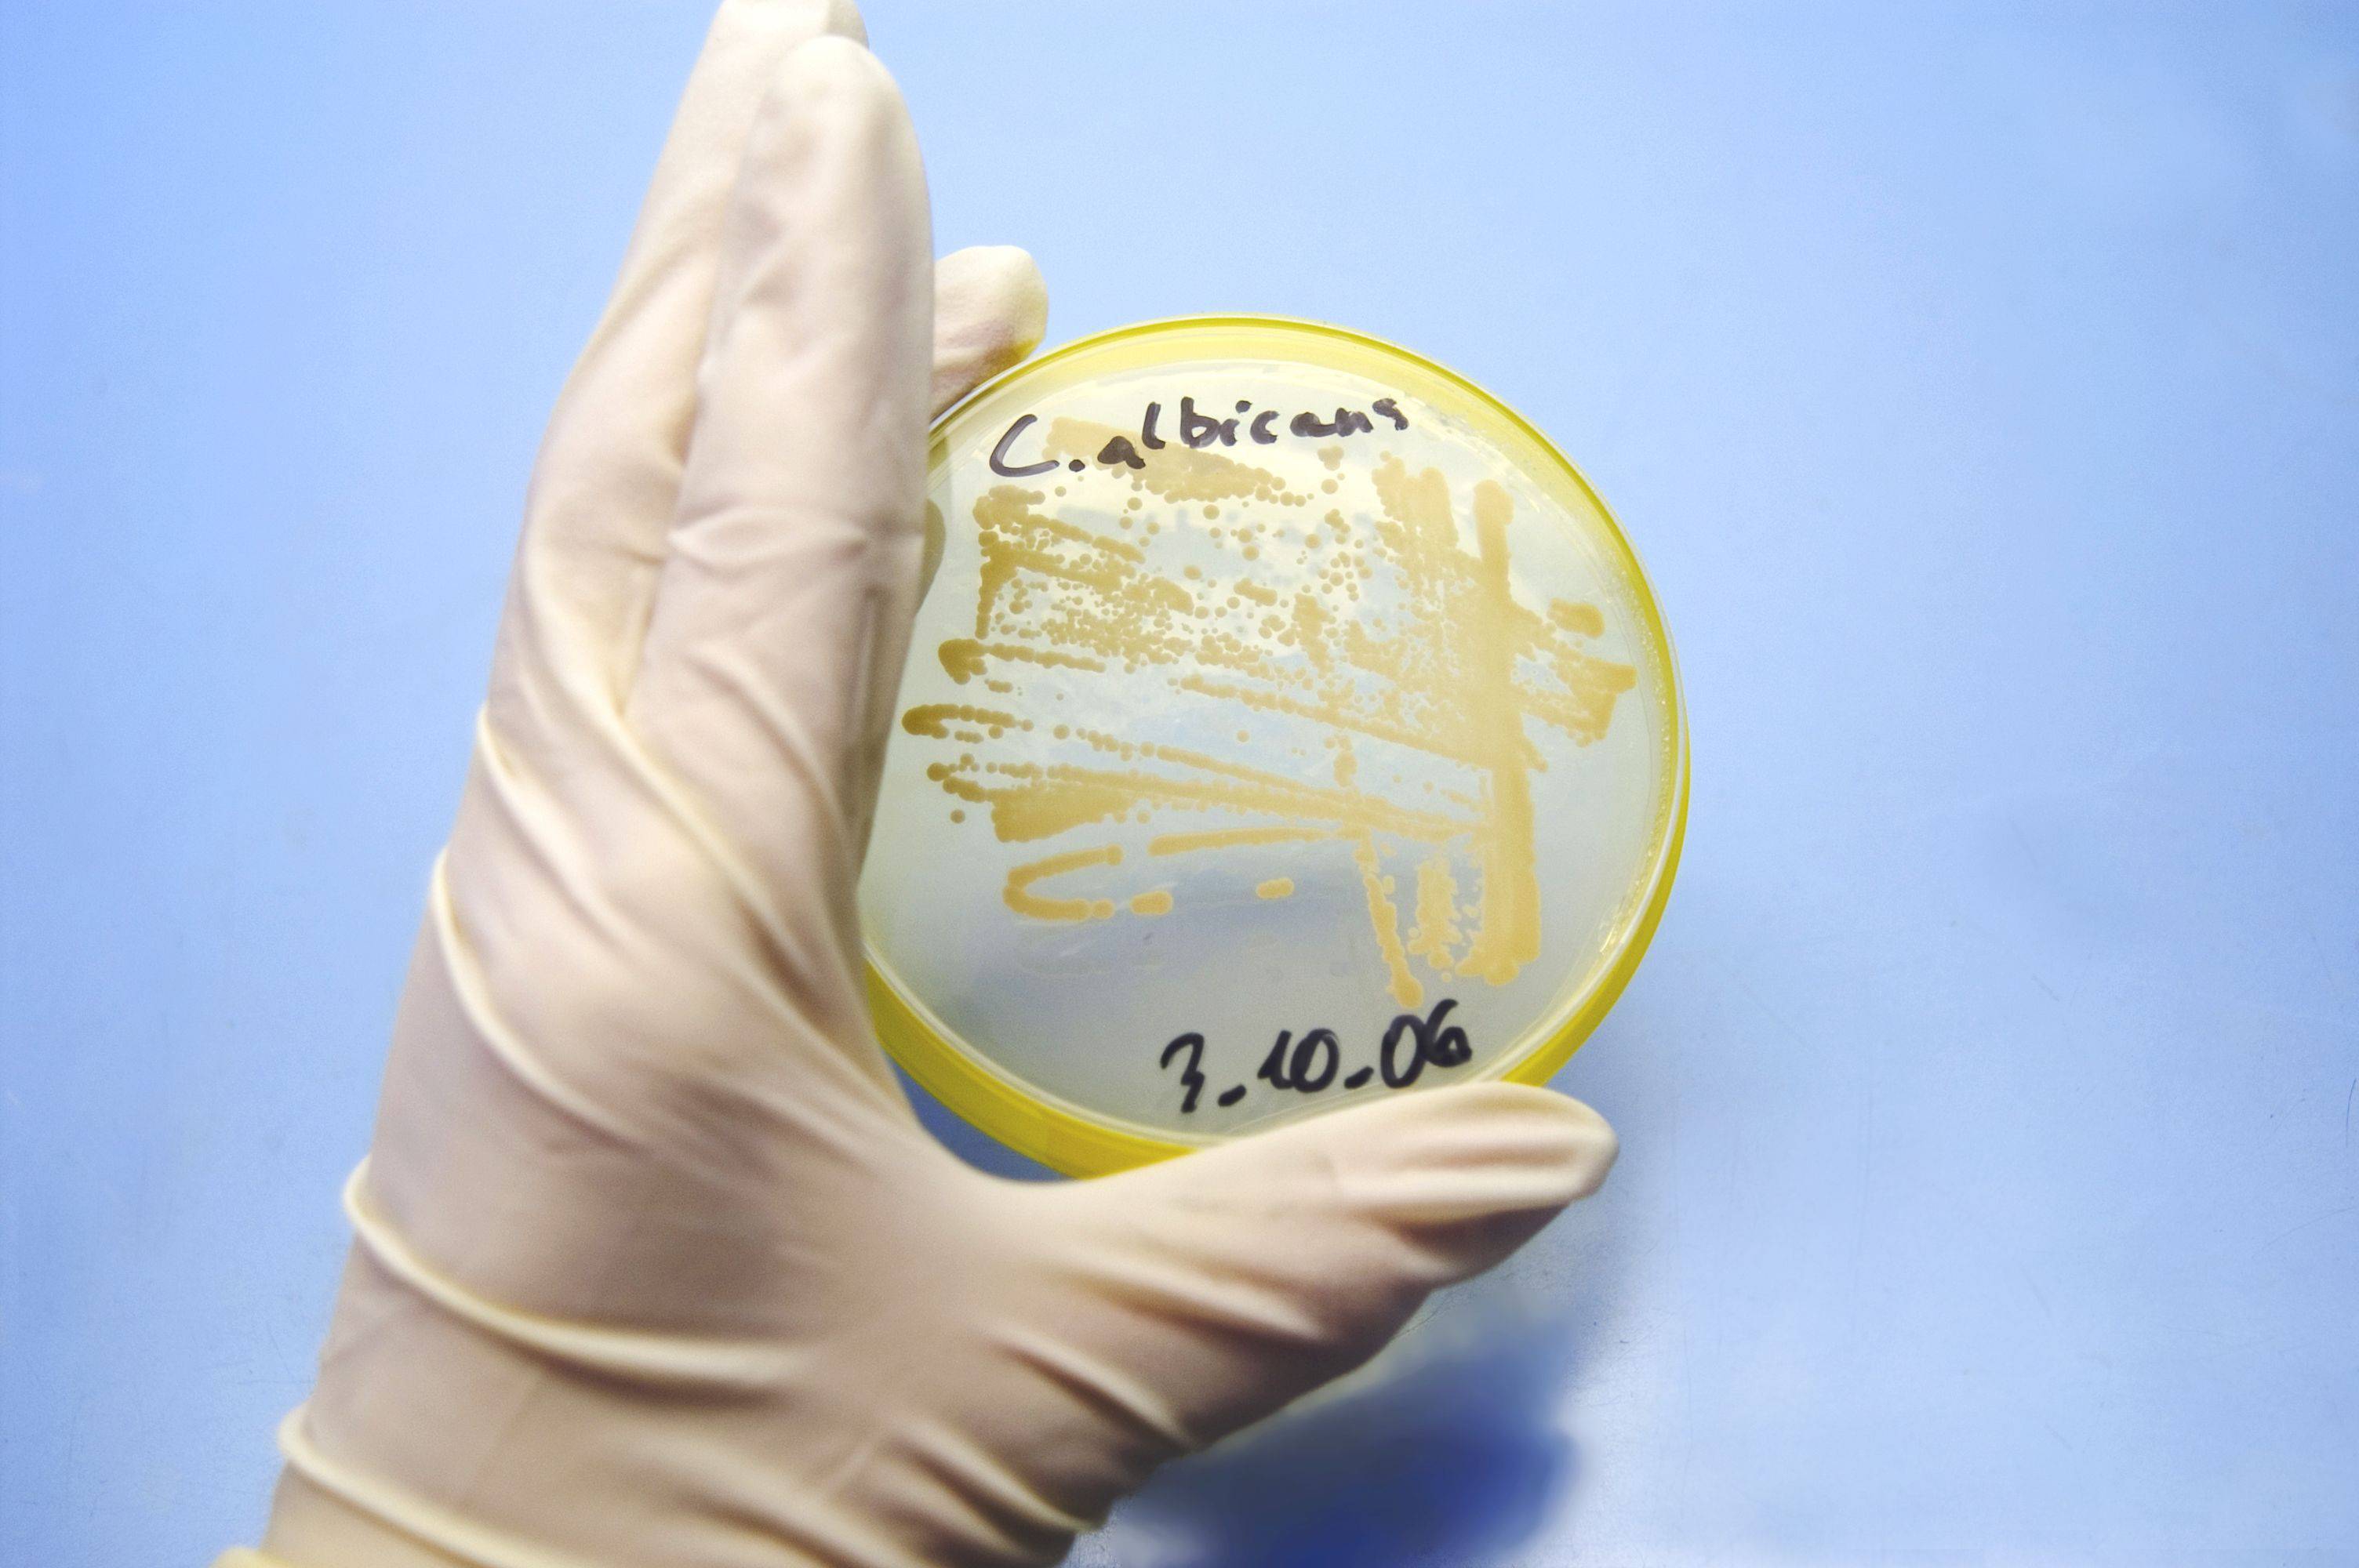

La candida albicans è un fungo generalmente presente nell‘intestino, spesso però si sposta nelle zone più intime di una povera donna e allora iniziano i “guai”.
->POTREBBE INTERESSARTI ANCHE: Candida riconoscerla e curarla
Infatti questo fungo non è tanto pericoloso quanto fastidioso, quando migra nelle nostre parti intime iniziano una serie di fastidi tipo: bruciore, prurito, rossore e perdite che presentano anche un cattivo odore.
Almeno una volta nella vita a tutte le donne è successo, ma purtroppo ci sono organismi più deboli e soggetti alla proliferazione di questa candida albicans.
Così molte donne si ritrovano a doverci litigare più volte nell’arco dell’anno.
E’ semplice usare farmaci antimicotici locali come ovuli, creme e relative lavande, se poi si tende ad avere più recidive allora si passa ad antimicotici per via orale.
Quando però veramente un mese si e un mese no si litiga con quest’ospite indesiderato iniziamo anche a chiederci se è il caso di riprendere di nuovo una terapia farmacologica o provare qualcosa di più naturale che ci aiuti magari anche dopo la cura data dal medico a evitare ricadute.
->POTREBBE INTERESSARTI ANCHE: Cinque cosa da sapere sulle piante di aloe
Ecco alcuni consigli:
- alimentazione ricca di proteine e fibre, ma povera di zuccheri di cui questo fungo ama nutrirsi, quindi evitare carboidrati e latticini che contengono il lattosio.
- spesso la candida migra dall’intestino alla vagina, quando trova uno squilibrio della flora intestinale, quindi è importante mantenere l’intestino sano regolarizzandone la funzionalità
Prodotti naturali!
- tea tree oil antifungino naturale, può essere utilizzato in compresse o anche ovuli e creme da applicare localmente
- fermenti lattici sono antagonisti della proliferazione della candida
- estratto di semi di pompelmo, reperibile in gocce o capsule
- vitamine come la biotina che facilita l’equilibrio della flora batterica intestinale , e la vitamina C che fortifica il nostro sistema immunitario
Se poi vogliamo un ulteriore aiuto sempre non chimico possiamo rivolgerci all’omeopatia:
- Helonias dioica 5 CH durante gli attacchi acuti prenderne 5 granuli per tre volte al giorno
- Candida albicans 15 CH durante la candidosi 5 granuli tutti i giorni, in stato di benessere tre granuli al giorno per evitare le recidive
Ulteriori accorgimenti
Questo è tutto ciò che possiamo fare in ambito curativo poi è possibile aggiungere altri accorgimenti tipo:
- biancheria di puro cotone e bianca
- no salvaslip, rende umido l’ambiente
- asciugarsi bene dopo il bidet per evitare l’ambiente umido tanto amato da questo fungo
- asciugamani personali e disinfettare i sanitari
Vi abbiamo fatto un quadro generale di come poter combattere questo antipatico fungo ora vi rimane solo che attuare i consigli dati.